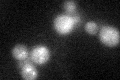

View description
Fatty-acyl coenzyme A oxidase, involved in the fatty acid beta-oxidation pathway; localized to the peroxisomal matrix
Localization:
Intensity:
Fold change:
Significance:
-
C’ GFP library in SD

below threshold15.97 -
N' NOP1pr-GFP in SD

punctate39.0503 -
N' TEF2pr-mCherry in SD

punctate57.2977 -
N' NATIVEpr-GFP in SD

punctate18.8547 -
N' TEF2pr-VC and Cyto-VN in SD

punctate24.4868 -
C’ GFP library in SD+DTT
cytosol18.611.16No -
C’ GFP library in SD+H2O2

cytosol21.941.37No -
C’ GFP library in Starvation Media

cytosol16.71.04No -
C’ GFP library on the background of Pup2-DaMP

below threshold -
C’ GFP library on the background of CCT mutant

below threshold17.61441.10284No
